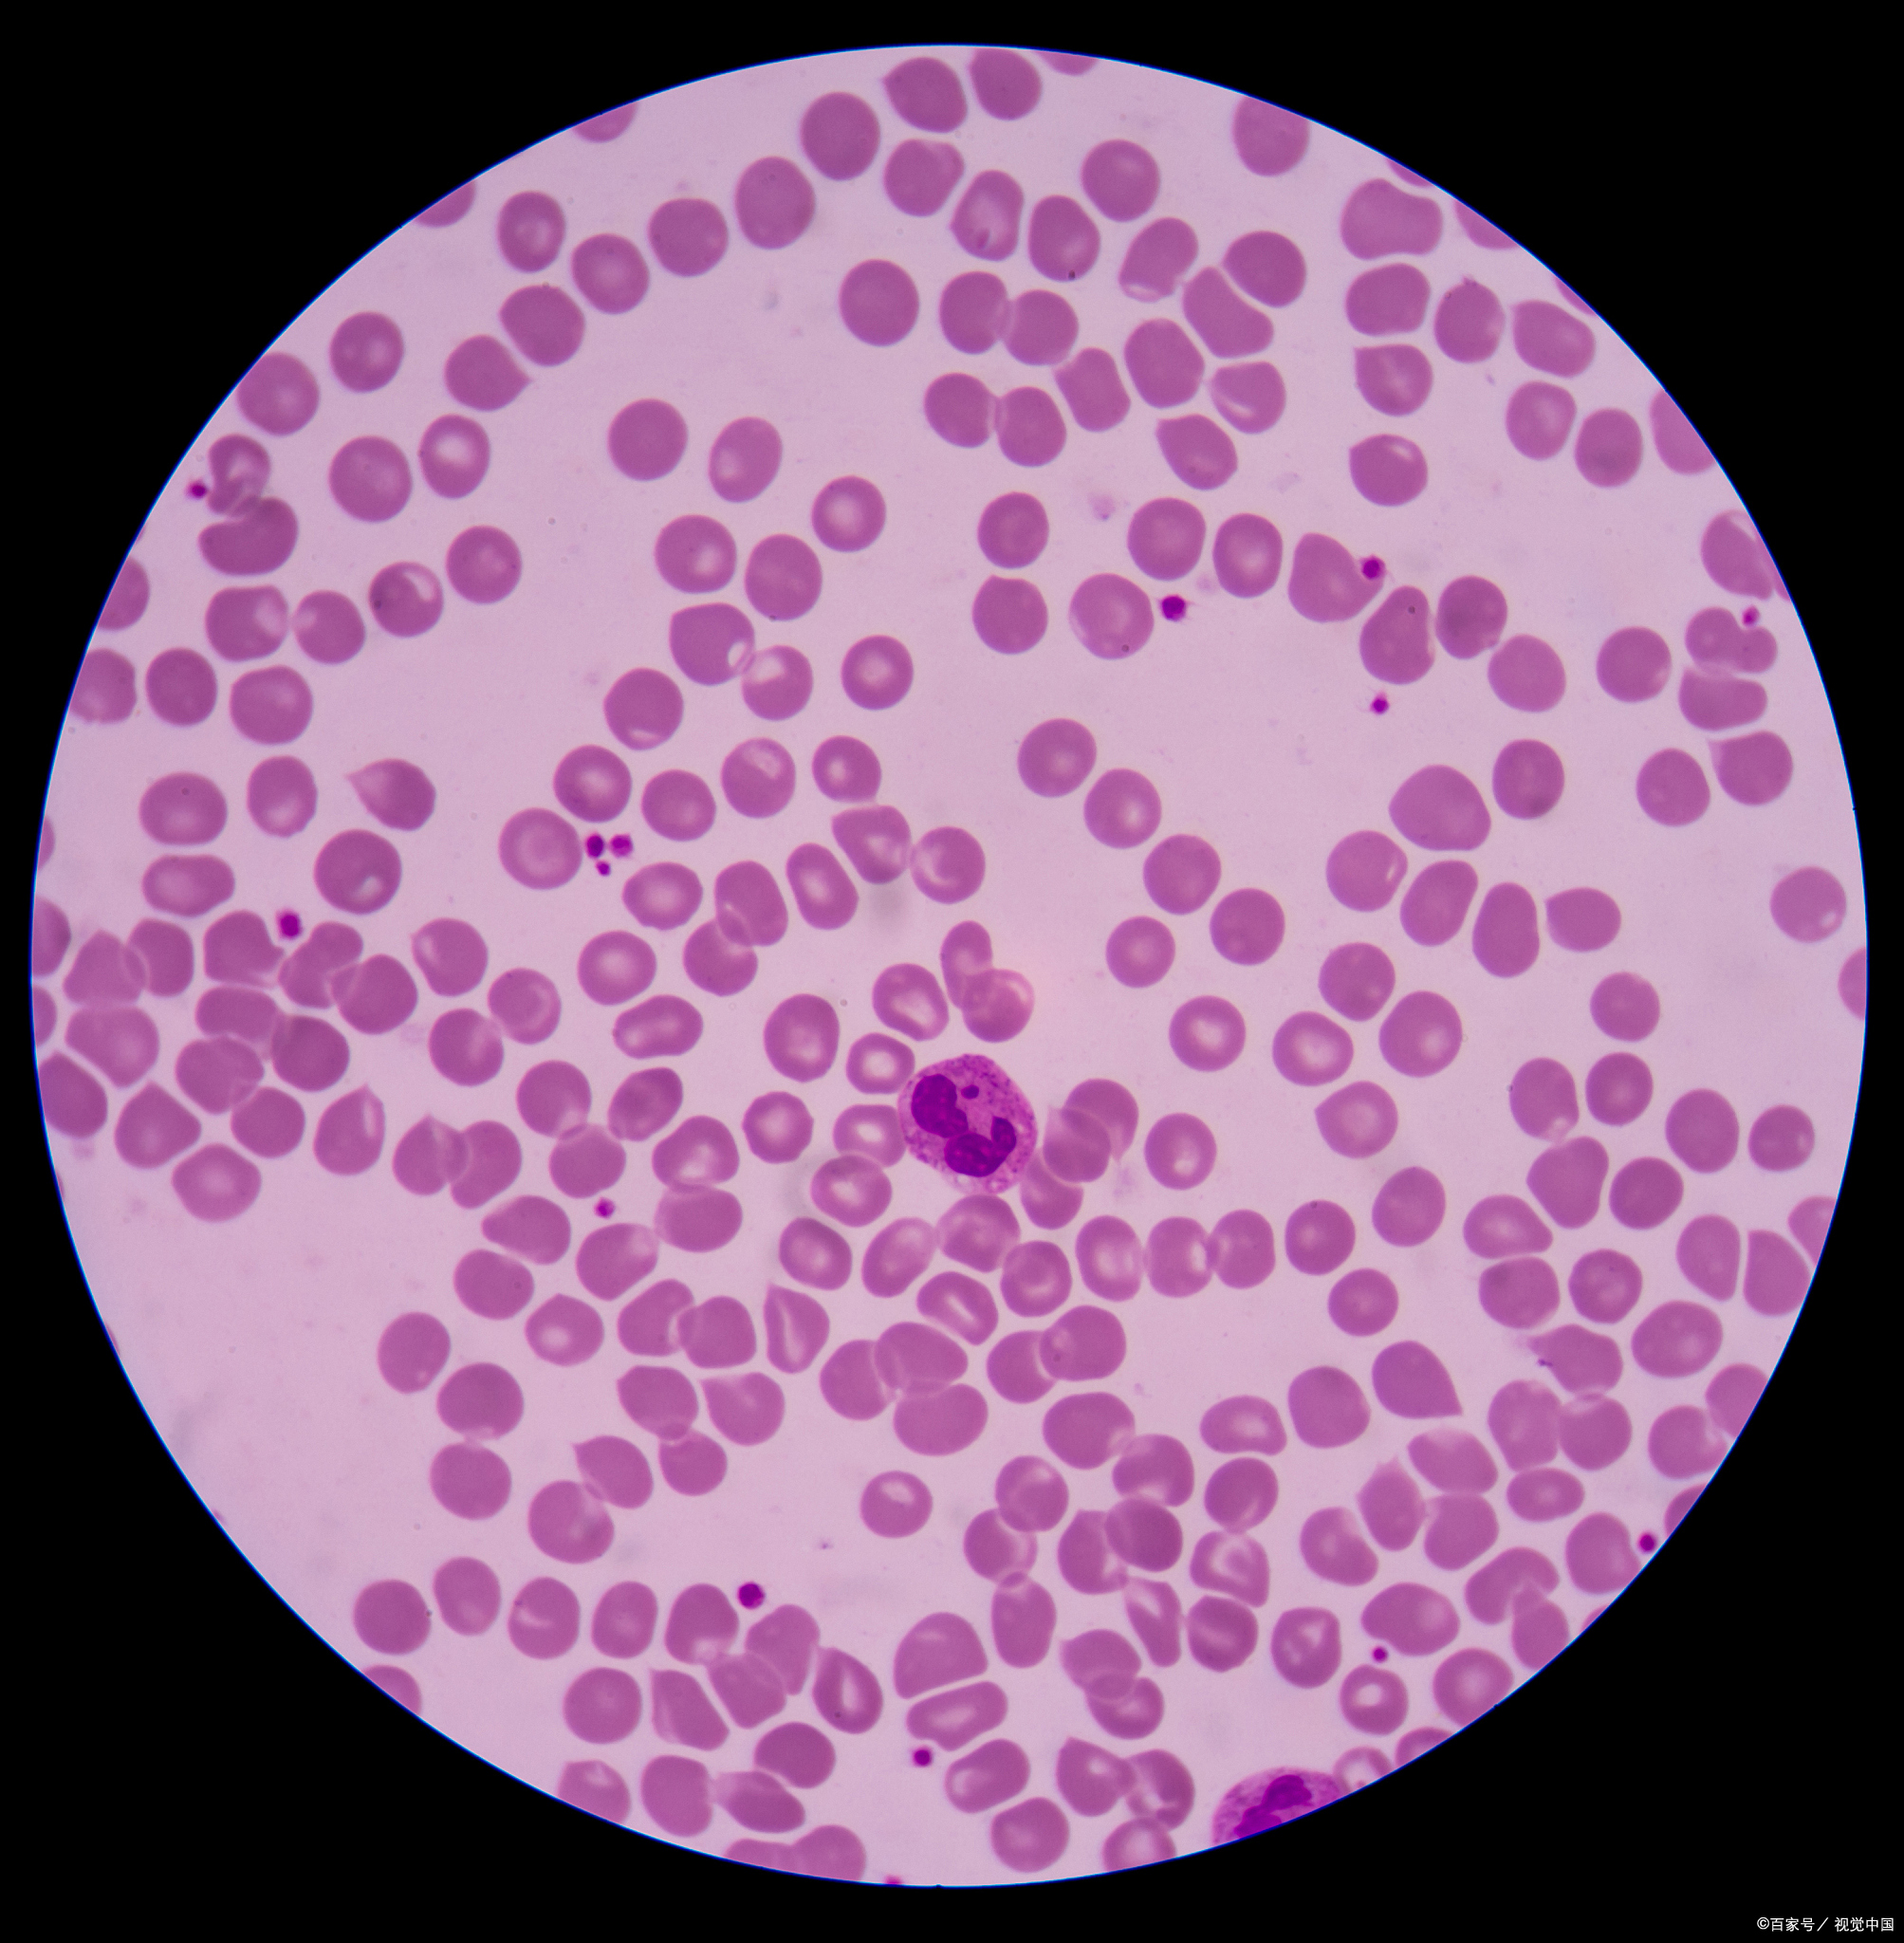

诊断需综合评估平均血小板体积偏低单独出现无法确诊疾病,需结合血常规中其他指标如血小板计数血红蛋白水平骨髓穿刺自身抗体检测等进一步检查例如,若同时存在血红蛋白降低,可能提示贫血合并血小板异常若血小板计数正常,则更可能与生成或破坏环节相关治疗与日常管理医生会根据病因制定方案若。
平均血小板体积MPV偏低意味着血小板平均体积小于正常范围,可能提示以下情况,但需结合其他指标综合判断一MPV偏低的潜在原因 血小板生成减少骨髓造血功能减退如再生障碍性贫血化疗药物或某些抗生素如磺胺类影响维生素B12叶酸缺乏等,可能导致血小板生成不足且体积偏小血小板破坏增加免疫。
若仅平均血小板体积偏低,但血小板数量正常,可能为生理性波动或非病理性因素导致例如,部分健康人群因个体差异或检测误差可能出现轻度偏低,通常无需特殊处理若平均血小板体积与血小板数量同时降低,需警惕病理性原因常见疾病包括骨结核骨髓炎骨髓纤维化及白血病等这些疾病会导致骨髓造血功能受损,使。
平均血小板体积偏低的相关信息如下正常范围平均血小板体积MPV是通过自动化血细胞分析仪测得的指标,其正常范围为9到13飞升该指标反映血小板的大小,对鉴别血小板减少的原因具有临床意义临床意义平均血小板体积偏低,最常见于以下情况再生障碍性贫血该疾病会导致骨髓造血功能衰竭,血小板生成减少。
血小板平均体积正常范围是711fl,低于7fL就是偏低引起血小板平均体积偏低,最常见的原因是骨髓造血功能不良性疾病,常见的是再生障碍性贫血还有约一半的急性白血病的病人,血小板的平均体积也偏低如果血小板平均体积,随着血小板的数量而逐渐下降,这是骨髓造血功能逐渐衰竭的表现所以血小板平均体积偏低。
平均血小板体积MPV偏低指检测结果低于正常参考值711fl,其可能原因及临床意义如下一生成减少相关因素骨髓造血功能异常是核心原因之一例如,再生障碍性贫血患者因骨髓造血干细胞增殖分化受抑制,导致血小板生成减少白血病患者因白血病细胞占据骨髓造血空间,抑制正常血小板前体细胞生成,均可能引发。
平均血小板体积MPV偏低提示血小板体积较小,可能与以下因素相关,需结合具体病因分析1 骨髓造血功能受损骨髓是血小板生成的主要场所,若造血功能异常,可能导致血小板体积偏小常见原因包括造血原料缺乏如铁维生素B12叶酸等缺乏,影响血小板生成骨髓造血衰竭如再生障碍性贫血骨髓纤维化等。
转载请注明来自极限财经,本文标题:《平均血小板体积偏低正常吗》
京公网安备11000000000001号
京ICP备11000001号
还没有评论,来说两句吧...